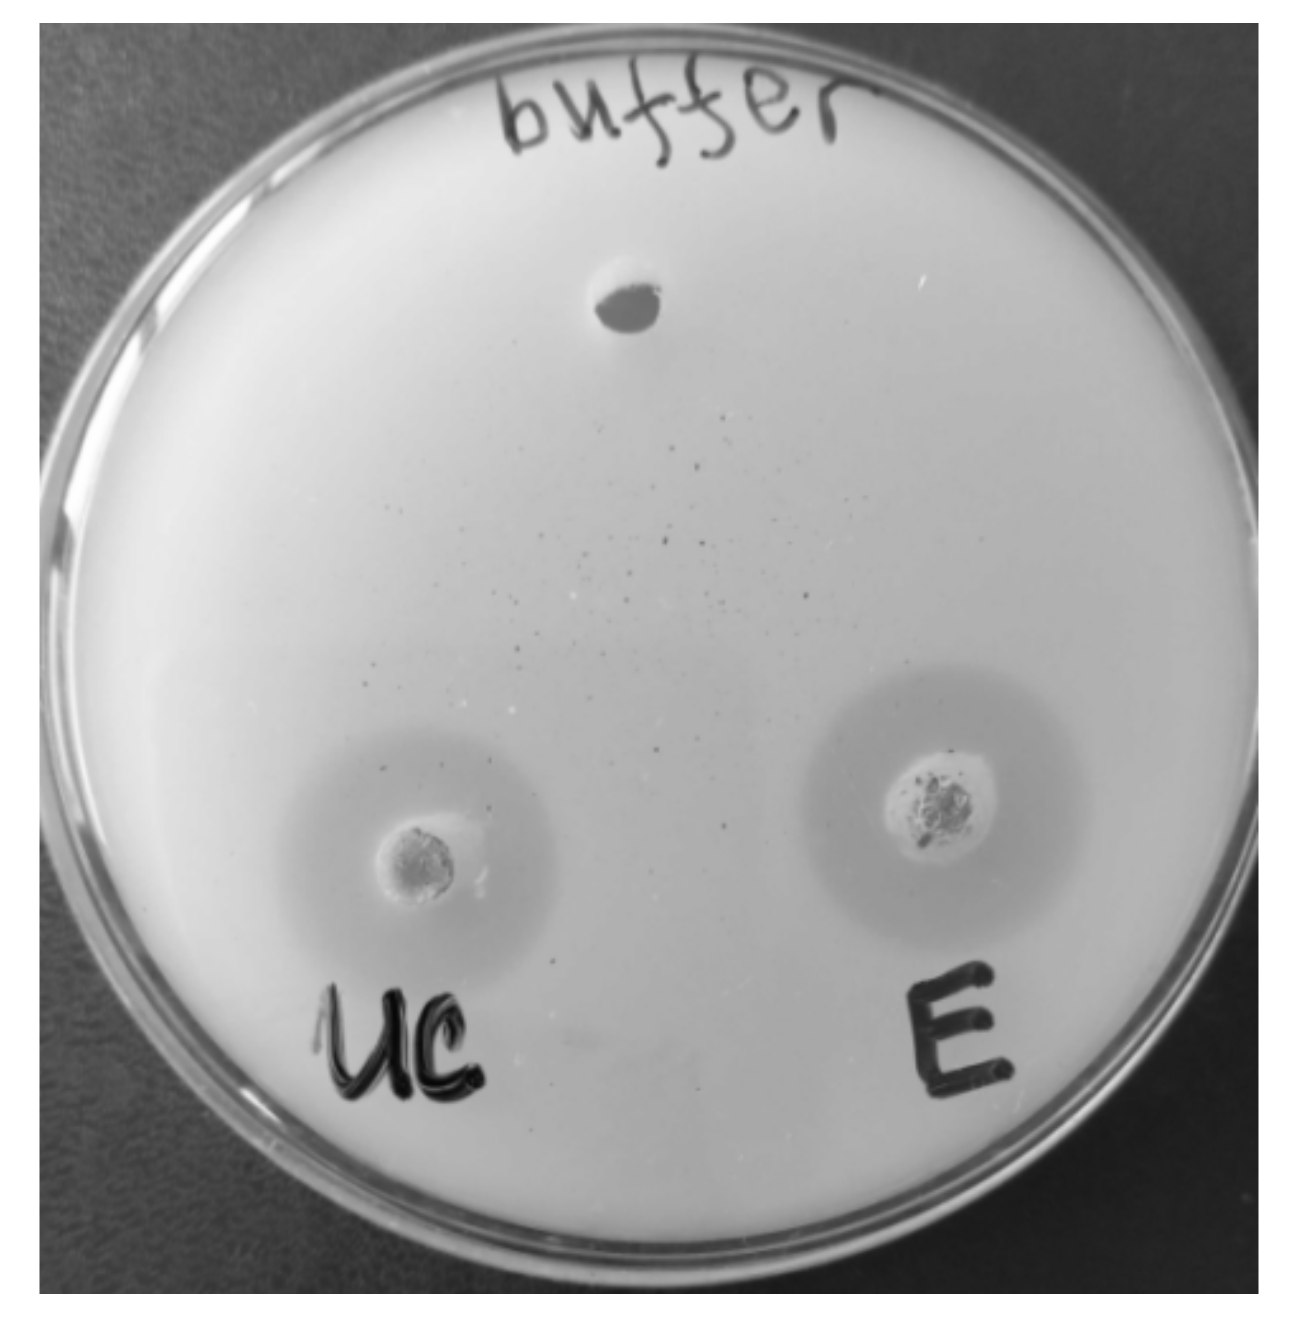
Biotech 12 00023 g002 Biotech 12 00023 g002

A Thermostable Lipase Isolated from Brevibacillus thermoruber Strain 7 Degrades Ɛ-Polycaprolactone
Abstract
1. Introduction
2. Materials and Methods
2.1. Microorganism
2.2. Media and Culture Conditions
2.3. Enzyme Assay
2.4. Enzyme Purification
2.5. Gel Permeation Chromatography
2.6. Characterization of the Purified Lipase Properties
2.7. Scanning Electron Microscopy (SEM)
3. Results
3.1. Enzyme Purification
3.2. Lipase Properties
3.3. Biodegradation Products as a Result of the Enzyme Action
3.4. SEM Investigations of the Morphological Changes
4. Discussion
5. Conclusions
Author Contributions
Funding
Institutional Review Board Statement
Informed Consent Statement
Conflicts of Interest
References
- Atanasova, N.; Paunova-Krasteva, T.; Stoitsova, S.; Radchenkova, N.; Boyadzhieva, I.; Petrov, K.; Kambourova, M. Degradation of poly (ε-caprolactone) by a thermophilic community and Brevibacillus thermoruber strain 7 isolated from Bulgarian hot spring. Biomolecules 2021, 11, 1488. [Google Scholar] [CrossRef]
- Müller, R.-J.; Schrader, H.; Profe, J.; Dresler, K.; Deckwer, W.-D. Enzymatic degradation of Poly(ethylene terephthalate): Rapid hydrolyse using a hydrolase from T. fusca. Macromol. Rapid Commun. 2005, 26, 1400–1405. [Google Scholar] [CrossRef]
- Pathak, V.M. Review on the current status of polymer degradation: A microbial approach. Bioresour. Bioprocess. 2017, 4, 15. [Google Scholar] [CrossRef]
- Stock up with Wholesale Supplies of Polycaprolactone Price. Available online: https://www.alibaba.com/showroom/polycaprolactone-price.html (accessed on 8 February 2023).
- Tokiwa, Y.; Calabia, B.P.; Ugwu, C.U.; Aiba, S. Biodegradability of plastics. Int. J. Mol. Sci. 2009, 10, 3722–3742. [Google Scholar] [CrossRef] [PubMed]
- Li, F.; Yu, D.; Lin, X.; Liu, D.; Xia, H.; Chen, S. Biodegradation of poly (ε-caprolactone) (PCL) by a new Penicillium oxalicum strain DSYD05-1. World J. Microbiol. Biotechnol. 2012, 28, 2929–2935. [Google Scholar] [CrossRef]
- Balkova, R.; Hermanova, S.; Voberkova, S.; Damborsky, P.; Richtera, L.; Omelkova, J.; Jancar, J. Structure and morphology of microbial degraded poly (ε-caprolactone)/graphite oxide composite. J. Polym. Environ. 2014, 22, 190–199. [Google Scholar] [CrossRef]
- Motiwalla, M.J.; Punyarthi, P.P.; Mehta, M.K.; D’Souza, J.S.; Kelkar-Mane, V. Studies on degradation efficiency of polycaprolactone by a naturally occurring bacterium. J. Environ. Biol. 2013, 34, 43–49. Available online: https://www.researchgate.net/publication/256450233 (accessed on 13 January 2013).
- Sekiguchi, T.; Saika, A.; Nomura, K.; Watanabe, T.; Fujimoto, Y.; Enoki, M.; Sato, T.; Kato, C.; Kanehiro, H. Biodegradation of aliphatic polyesters soaked in deep seawaters and isolation of poly (ε-caprolactone)-degrading bacteria. Polym. Degrad. Stab. 2011, 96, 1397–1403. [Google Scholar] [CrossRef]
- Urbanek, A.K.; Rymowicz, W.; Mirończuk, A.M. Degradation of plastics and plastic-degrading bacteria in cold marine habitats. Appl. Microbiol. Biotechnol. 2018, 102, 7669–7678. [Google Scholar] [CrossRef]
- Hadad, D.; Geresh, S.; Sivan, A. Biodegradation of polyethylene by the thermophilic bacterium Brevibacillus borstelensis. J. Appl. Microbiol. 2005, 98, 1093–1100. [Google Scholar] [CrossRef]
- Yan, F.; Wei, R.; Cui, Q.; Bornscheuer, U.T.; Liu, Y. Thermophilic whole-cell degradation of polyethylene terephthalate using engineered Clostridium thermocellum. Microb. Biotechnol. 2021, 14, 374–385. [Google Scholar] [CrossRef] [PubMed]
- Mahdi, M.S.; Ameen, R.S.; Ibrahim, H.K. Study on degradation of nylon 6 by thermophilic bacteria Anoxybacillus rupiensis Ir3 (JQ912241). Int. J. Adv. Res. Biol. Sci. 2016, 3, 200–209. [Google Scholar] [CrossRef]
- Tomita, K.; Hayashi, N.; Ikeda, N.; Kikuchi, Y. Isolation of a thermophilic bacterium degrading some nylons. Polym. Degrad. Stab. 2003, 81, 511–514. [Google Scholar] [CrossRef]
- Nakasaki, K.; Matsuura, H.; Tanaka, H.; Sakai, T. Synergy of two thermophiles enables decomposition of poly-ε-caprolactone under composting conditions. FEMS Microbiol. Ecol. 2006, 58, 373–383. [Google Scholar] [CrossRef] [PubMed]
- Chua, T.K.; Tseng, M.; Yang, M.K. Degradation of Poly (ε-caprolactone) by thermophilic Streptomyces thermoviolaceus subsp. thermoviolaceus 76T-2. AMB Express 2013, 3, e8. [Google Scholar] [CrossRef] [PubMed]
- Atanasova, N.; Stoitsova, S.; Paunova-Krasteva, T.; Kambourova, M. Plastic degradation by extremophilic bacteria. Int. J. Mol. Sci. 2021, 22, 5610. [Google Scholar] [CrossRef]
- Danso, D.; Chow, J.; Streit, W.R. Plastics: Environmental and biotechnological perspectives on microbial degradation. Appl. Environ. Microbiol. 2019, 85, e01095-19. [Google Scholar] [CrossRef]
- Ahmed, T.; Shahid, M.; Azeem, F.; Rasul, I.; Shah, A.A.; Noman, M.; Hameed, A.; Manzoor, N.; Manzoor, I.; Muhammad, S. Biodegradation of plastics: Current scenario and future prospects for environmental safety. Environ. Sci. Pollut. Res. 2018, 25, 7287–7298. [Google Scholar] [CrossRef]
- Muhamad, W.N.A.W.; Othman, R.; Shaharuddin, R.I.; Irani, M.S. Microorganism as plastic biodegradation agent towards sustainable environment. Adv. Environ. Biol. 2015, 9, 8–14. Available online: https://www.researchgate.net/publication/332553623 (accessed on 6 June 2015).
- Oda, Y.; Oida, N.; Urakami, T.; Tonomura, K. Polycaprolactone depolymerase produced by the bacterium Alcaligenes faecalis. FEMS Microbiol. Lett. 1997, 152, 339–343. [Google Scholar] [CrossRef]
- Gupta, N.; Rathi, P.; Gupta, R. Simplified para-nitrophenyl palmitate assay for lipases and esterases. Anal. Biochem. 2002, 311, 98–99. [Google Scholar] [CrossRef] [PubMed]
- Almeida, E.L.; Carrillo Rincón, A.F.; Jackson, S.A.; Dobson, A.D. In silico screening and heterologous expression of a polyethylene terephthalate hydrolase (PETase)-like enzyme (SM14est) with polycaprolactone (PCL)-degrading activity, from the marine sponge-derived strain Streptomyces sp. SM14. Front. Microbiol. 2019, 10, 2187. [Google Scholar] [CrossRef] [PubMed]
- Lowry, O.H.; Rosenbrough, N.J.; Farr, A.L.; Randall, R.J. Protein measurement with the Folin phenol reagent. J. Biol. Chem. 1951, 193, 265–275. [Google Scholar] [CrossRef] [PubMed]
- Laemmli, U.K. Cleavage ofstructural proteins during the assembly of the head of bacteriophage T4. Nature 1970, 227, 680–685. [Google Scholar] [CrossRef]
- Ru, J.; Huo, Y.; Yang, Y. Microbial degradation and valorization of plastic wastes. Front. Microbiol. 2020, 11, 442. [Google Scholar] [CrossRef]
- Sharma, P.; Sharma, N.; Pathania, S.; Handa, S. Purification and characterization of lipase by Bacillus methylotrophicus PS3 under submerged fermentation and its application in detergent industry. J. Genet. Eng. Biotechnol. 2017, 15, 369–377. [Google Scholar] [CrossRef]
- Eko Sukohidayat, N.H.; Zarei, M.; Baharin, B.S.; Manap, M.Y. Purification and characterization of lipase produced by Leuconostoc mesenteroides subsp. mesenteroides ATCC 8293 using an aqueous two-phase system (ATPS) composed of triton X-100 and maltitol. Molecules 2018, 23, 1800. [Google Scholar] [CrossRef]
- Rowe, L.; Howard, G.T. Growth of Bacillus subtilis on polyurethane and the purification and characterization of a polyurethanase-lipase enzyme. Int. Biodeterior. Biodegrad. 2002, 50, 33–40. [Google Scholar] [CrossRef]
- Hu, X.; Thumarat, U.; Zhang, X.; Tang, M.; Kawai, F. Diversity of polyester-degrading bacteria in compost and molecular analysis of a thermoactive esterase from Thermobifida alba AHK119. Appl. Microbiol. Biotechnol. 2010, 87, 771–779. [Google Scholar] [CrossRef]
- Gajanand, E.; Soni, L.K.; Dixit, V.K. Biodegradable polymers: A smart strategy for today’s crucial needs. Crit. Rev. Pharm. Sci. 2014, 3, 1–70. [Google Scholar]
- Kawai, F.; Kawabata, T.; Oda, M. Current knowledge on enzymatic PET degradation and its possible application to waste stream management and other fields. Appl. Microbiol. Biotechnol. 2019, 103, 4253–4268. [Google Scholar] [CrossRef] [PubMed]
- Schmidt, J.; Wei, R.; Oeser, T.; Dedavid e Silva, L.; Breite, D.; Schulze, A.; Zimmermann, W. Degradation of polyester polyurethane by bacterial polyester hydrolases. Polymers 2017, 9, 65. [Google Scholar] [CrossRef] [PubMed]
- Barth, M.; Oeser, T.; Wei, R.; Then, J.; Schmidt, J.; Zimmermann, W. Effect of hydrolysis products on the enzymatic degradation of polyethylene terephthalate nanoparticles by a polyester hydrolase from Thermobifida fusca. Biochem. Eng. J. 2015, 93, 222–228. [Google Scholar] [CrossRef]
- Katiyar, M.; Ali, A. Effect of metal ions on the hydrolytic and transesterification activities of Candida rugosa lipase. J. Oleo Sci. 2013, 62, 919–924. [Google Scholar] [CrossRef]
- Cassia Pereira, J.; Giese, E.C.; de Souza Moretti, M.M.; dos Santos Gomes, A.C.; Perrone, O.M.; Boscolo, M.; da Silva, R.; Gomes, E.; Martins, D.A.B. Effect of metal ions, chemical agents and organic compounds on lignocellulolytic enzymes activities. In Enzyme Inhibitors and Activators; Senturk, M., Ed.; Intech Open Science: London, UK, 2017; pp. 139–164. [Google Scholar] [CrossRef]
- Yeboah, J.O.; Shi, G.; Shi, W. Effect of heavy metal contamination on soil enzymes activities. J. Geosci. Environ. Protect. 2021, 9, 135–154. [Google Scholar] [CrossRef]
- Gargouri, Y.; Julien, R.; Bois, A.G.; Verger, R.; Sarda, L. Studies on the detergent inhibition of pancreatic lipase activity. J. Lipid Res. 1983, 24, 1336–1342. [Google Scholar] [CrossRef]
- Wang, J.; Jia, R.; Wang, J.; Sun, Z.; Wu, Z.; Liu, R.; Zong, W. Investigation on the interaction of catalase with sodium lauryl sulfonate and the underlying mechanisms. J. Biochem. Mol. Toxicol. 2018, 32, e22025. [Google Scholar] [CrossRef]
- Oceguera-Cervantes, A.; Carrillo-García, A.; López, N.; Bolanos-Nunez, S.; Cruz-Gómez, M.J.; Wacher, C.; Loza-Tavera, H. Characterization of the polyurethanolytic activity of two Alicycliphilus sp. strains able to degrade polyurethane and N-methylpyrrolidone. Appl. Environ. Microbiol. 2007, 73, 6214–6223. [Google Scholar] [CrossRef]
- Yoshida, S.; Hiraga, K.; Takehana, T.; Taniguchi, I.; Yamaji, H.; Maeda, Y.; Toyohara, K.; Miyamoto, K.; Kimura, Y.; Oda, K. A bacterium that degrades and assimilates poly (ethylene terephthalate). Science 2016, 351, 1196–1199. [Google Scholar] [CrossRef]

| Purification Step | Volume, mL | Protein | Activity | Specific Activity, U/mg | Purification Factor, Fold | Yield, % | ||
|---|---|---|---|---|---|---|---|---|
| mg | % | Units | % | |||||
| Supernatant | 1470 | 292 | 100 | 138,181 | 100 | 473.2 | 1 | 100 |
| Ultraconcentrate | 5 | 110 | 37.7 | 79,040 | 57.2 | 717.9 | 1.5 | 57.2 |
| DEAE-Sepharose | 28 | 6.5 | 2.2 | 71,025 | 51.4 | 10,910 | 23.1 | 51.4 |
| Metal Ions (5 mM) | Relative Activity (%) | Detergents, Inhibitors (5 mM) | Relative Activity (%) |
|---|---|---|---|
| Control | 100 | Control | 100 |
| Ca2+ | 106.7 | EDTA disodium salt | 0 |
| Mg2+ | 93.3 | SDS | 4.5 |
| Co2+ | 93.3 | Tween 20 | 2.9 |
| K+ | 89.6 | DTT | 3.3 |
| Na+ | 80.0 | PMSF | 2.5 |
| Cu2+ | 80.0 | NaLS | 4.7 |
| Mn2+ | 80.0 | NBS | 2.8 |
| Hg2+ | 66.7 | ||
| Zn2+ | 66.7 | ||
| Fe3+ | 33.3 |
Disclaimer/Publisher’s Note: The statements, opinions and data contained in all publications are solely those of the individual author(s) and contributor(s) and not of MDPI and/or the editor(s). MDPI and/or the editor(s) disclaim responsibility for any injury to people or property resulting from any ideas, methods, instructions or products referred to in the content. |
© 2023 by the authors. Licensee MDPI, Basel, Switzerland. This article is an open access article distributed under the terms and conditions of the Creative Commons Attribution (CC BY) license (https://creativecommons.org/licenses/by/4.0/).
Share and Cite
Atanasova, N.; Paunova-Krasteva, T.; Kambourova, M.; Boyadzhieva, I. A Thermostable Lipase Isolated from Brevibacillus thermoruber Strain 7 Degrades Ɛ-Polycaprolactone. BioTech 2023, 12, 23. https://doi.org/10.3390/biotech12010023
Atanasova N, Paunova-Krasteva T, Kambourova M, Boyadzhieva I. A Thermostable Lipase Isolated from Brevibacillus thermoruber Strain 7 Degrades Ɛ-Polycaprolactone. BioTech. 2023; 12(1):23. https://doi.org/10.3390/biotech12010023
Chicago/Turabian StyleAtanasova, Nikolina, Tsvetelina Paunova-Krasteva, Margarita Kambourova, and Ivanka Boyadzhieva. 2023. "A Thermostable Lipase Isolated from Brevibacillus thermoruber Strain 7 Degrades Ɛ-Polycaprolactone" BioTech 12, no. 1: 23. https://doi.org/10.3390/biotech12010023
APA StyleAtanasova, N., Paunova-Krasteva, T., Kambourova, M., & Boyadzhieva, I. (2023). A Thermostable Lipase Isolated from Brevibacillus thermoruber Strain 7 Degrades Ɛ-Polycaprolactone. BioTech, 12(1), 23. https://doi.org/10.3390/biotech12010023

